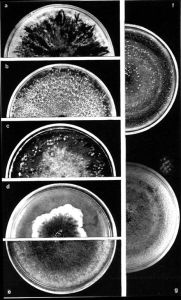
櫟殼二孢

櫟殼二孢
| 拉丁綱名 | Fungi Imperficti |
| 中文綱名 | 半知菌綱 |
| 拉丁目名 | Sphaeropsidales |
| 中文目名 | 殼霉目 |
| 拉丁科名 | Sphaeropsicaceae |
| 中文科名 | 殼霉科 |
| 拉丁名 | Ascochyta quercus |
| 中文名 | 櫟殼二孢 |
| 定名人 | Sacc. et Speg. |
| 參考文獻 | Sphaeropsicaceae |
櫟殼二孢,生物,菌類,殼霉科。
| 拉丁綱名 | Fungi Imperficti |
| 中文綱名 | 半知菌綱 |
| 拉丁目名 | Sphaeropsidales |
| 中文目名 | 殼霉目 |
| 拉丁科名 | Sphaeropsicaceae |
| 中文科名 | 殼霉科 |
| 拉丁名 | Ascochyta quercus |
| 中文名 | 櫟殼二孢 |
| 定名人 | Sacc. et Speg. |
| 參考文獻 | Sphaeropsicaceae |
"赤桐定匙羹藤酸I齒阿米醇齒阿米定齒阿米素L-赤-二氨鵝膏蕈氨酸赤霉酸赤石脂赤松素赤松素甲醚赤蘚醇蟲草素臭椿苦酮臭椿酮臭椿酯酮臭豆鹼(+)-臭蟲蟻二醛臭...
厚殼烯酮內酯 相關知識炭殼屬(Daldinia)。1.4 柔膜菌目(Helotiales)(1...
簡介 形態特徵 繁殖方式 下屬分類 下屬特徵蓋 Daedalae quercina櫟迷孔菌 6、擔子:由擔子果中生殖...Cantharellaceae 革菌型: 2、粉孢革菌科... 孔狀菌型:18、刺孢多孔菌科Bondarzewiaceae 19、牛排菌...
概述 形態特徵 下屬科 分科依據 分類》、《悼念彭雪楓將軍》等雜誌書集發表。二00九年榮獲《開國大典》詩詞藝術...”榮譽稱號。榮獲“二00九年度全國中華詩詞華表獎”並授予“二00九年度全國...。榮獲“二00九年《中華藝術名人榜》古詞十佳”榮譽稱號。《鶯啼序》榮獲...
櫟、楊、榕、槐等120多種闊葉樹的腐木上,單生或群生。人工培植以椴木的和...
介紹 類群劃分 典型品種 生態環境 食用價值、清水、高沖、馬畈、龍沖、二嶺、潘沖、福德、長棚、杜廟、曹棚、楊家、劉橋...、黑木耳、雙孢蘑菇四大品類和山區、丘陵、畈區各具特色的三大板塊,成為農民...樹種最豐富、分布也較廣。 孛畈鎮 1、麻櫟、栓皮櫟群落。廣布於境內北部...
行政區劃 簡介 現任領導 地理區域 自然資源為縱裂平行脈而同型者。葉雙型(Dimorphic frond):孢子葉與營養葉大小、形狀不同者。孢子葉(Fertile frond):具孢子的實...(Microspore):雄配子體產生之小型孢子。小孢子葉(Microsporophyll...
蕨類植物 種子植物區別證據。被子植物在形態上具有不同於裸子植物所具有的孢子葉球的花;胚珠被...出了“花球果”假說,認為被子植物的花是一個由裸子植物的孢子葉球演變來...確信被子植物是單元發生的。孢粉超微結構方面的研究給這一信念以重要的支持...
基本信息 起源 功能 衍征 分類系統